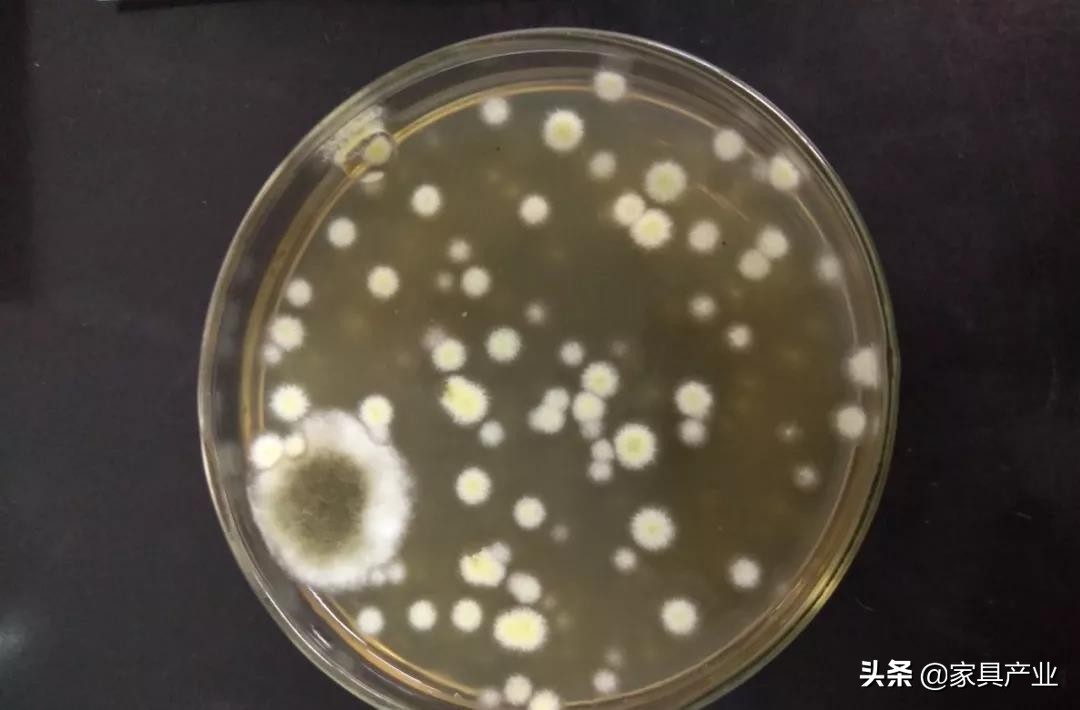
南方人家里一年四季都在发霉？这份除霉秘籍快收好

你这么霉~这么霉~你这么霉霉霉霉~~

北方的小伙伴在寒夜里四季如春,而南方的小伙伴却在雨季里四季发霉。

衣服鞋子、橱柜水槽、墙面空调,甚至……连眼影都会发霉。

层出不穷的“霉”问题,让人着实“霉”办法。

很多南方地区,哪有春季夏季秋季冬季?明明一年四季都是雨季!潮湿的环境,为霉菌的繁殖生长提供了完美的气候条件。
并且霉菌在室内和室外都能生长,孢子粉会随空气流动,会在粘附物体表迅速繁殖蔓延,并释放出难闻、刺鼻的异味。

这场人菌大战,一触即发!有人说想看产业哥的除霉秘籍,今天,它来了!
衣物发霉
为什么衣服、被子在南方销量居高不下?因为每当雨季过后,南方的盆友必定集体吐槽,整个衣柜的衣服又全军覆没啦!被子又成霉菌培养皿啦!

就算把衣服和被褥塞进收纳袋,再抽成真空,生命力极其顽强的霉菌也有办法在里头“开枝散叶”。

更何况发霉这事,往往是发生在我们眼皮子底下的。连下一周大雨你再看,别说挂在柜子里的衣物,就算晾在阳台上的都能原地发霉。尤其是夏天穿过的带汗渍的T恤,在脏衣篓里“腌”上一夜,第二天那叫一个斑斓……

所以有不少自暴自弃的南方朋友,只穿深色系,任你长斑发霉,反正我眼不见为净。

衣服及时洗净、晒干,是最好的预防发霉的方式。否则你会发现没有洗干净的领口、袖口,日益泛黄长霉。

但如果衣服已经发霉了,又舍不得丢怎么办?不妨试试除斑除霉类的洗衣剂。普通的棉织品,用含生物酶的氧系清洗剂,可以分解掉霉菌,达到除霉的效果。
其实衣物的发霉之源,终究是因为潮湿。所以…抓紧除湿不就好了吗?各式各样的除湿盒,吸湿产品,是南方小“霉”女的必囤神器。这种氯化钙、活性炭颗粒组成的除湿盒,能够吸收潮湿空气里的水分,降低室内湿度。听说最潮的地方,三五天就得消耗掉一个……

除了除湿盒,也可以选择*湿机除**。市面上现有的*湿机除**,有冷冻式*湿机除**和转轮式*湿机除**。冷冻式*湿机除**,房间的湿度越高,除湿效果越好,但在低温低湿的条件下没法工作。轮转式*湿机除**,除湿效果不受到湿度温度的影响。但比较费电,价格也相对较高。

Tips:没有*湿机除**,没买除湿盒,打开空调的除湿模式也能应急哦。
皮具发霉
最令女人绝望的是什么?那就是发现自己才一段时间没背过的包包,发霉了……

最令男人绝望的是什么?才一段时间没穿过的皮鞋,长毛了……

在三天不洗澡都感觉要发霉的气候里,任你什么皮衣、皮沙发,统统发霉没商量。何况真皮制品有脂肪、蛋白质,极其容易吸引霉菌在上面繁殖。

鞋包、皮衣、皮带之类的皮质物品,要在开放、通风、干燥的环境收藏。包包放进柜子前,可以塞满报纸或者其他除湿产品,让它们能够随时“呼吸”到干燥的空气。否则一旦发霉,你就会发现无论怎么擦拭,它们很快又会卷土重来。

如果皮具已经发霉,首先得让皮具通风干燥,轻轻扫去表面的霉灰,用湿水后拧干的软布擦拭,尽可能的多次清洗软布,以免残留。

等到皮具再次干燥,可以用干抹布沾一些皮具清洁剂,用画圈圈的模式摩擦,然后打上一层透明蜡,自然风干。这样既有光泽,又能防止水汽入侵,对抗潮湿的环境。

厨卫发霉
厨房里那块祖传的木头菜板,真真是极容易发霉的物件。要问家居君怎么才能给木菜板除霉?那家居君只能发自内心的说一句,别除了,换一块吧!

发霉的大米不能吃,发霉的菜板也不能用啊!!!清洁不当的菜板,上面的细菌霉菌比马桶里的还要多。

现在已经有很多不同材质的菜板可供我们选择了,比如不锈钢菜板、复合塑料菜板。都有抗菌防霉,易清洗的优点。

不过不锈钢伤刀刃,塑料容易有划痕,无法做到尽善尽美。但稻壳压制的防霉菜板,材质致密,硬度与钢铁相似。难留划痕,也不易滋生细菌,是木头菜板的完美替代品。

而厨房水槽的缝隙、卫生间马桶边缘、洗手盆缝隙……这些长期处在多油多水环境中的犄角旮旯,才是室内发霉真正的重灾区。如果不及时更换,霉菌不仅会布满密封条,更会发黄发黑,发出恶臭。

有些密封胶是微孔结构,非常容易吸附各种有机物。再加上潮湿与不通风的环境,分分钟发霉给你看。所以想要一劳永逸,还是得靠防霉的玻璃胶来拯救。

铲掉脏兮兮的密封胶。

用上防霉玻璃胶,四舍五入等于换了一个新水槽。

但要是已经发霉,又不想重新进行“微装修”,那除霉啫喱就可以出来大显身手了。

先把发霉的地方擦干,不能留下残水,然后再把除霉啫喱涂抹在发霉的区域。

然后静置几小时,等待霉菌的灭亡,最后冲洗掉即可。

墙面发霉
霉菌可是相当有野心的生物,比起家里的边边角角,它们想要占领的终极领地其实是——墙面!当霉菌占领了大片大片的墙壁,那种嚣张的态势,就差把你们家房本改姓“霉”了。

想要预防墙面发霉,在装修时给浴室、外窗、阳台等易受潮的地方做好防水……路人甲骂骂咧咧:我家墙都快霉成毛毯了,还讲啥预防?好好好,产业哥这就告诉你们如果墙面已经发霉,该如何处理。

如果墙壁只是刚刚产生霉斑,一定要立即用墙面防霉剂喷洒,及时杀死霉菌孢子,阻止它们继续在墙面繁衍生息。

但发霉的较为严重时,除了清洁修复,最关键的是要找到发霉原因。比如卫生间墙面外部靠下的部分发霉、脱皮,则说明防水没有做好。如果停止使用卫生间一段时间,墙面还是潮湿发霉,那就是水管漏了。

靠窗的墙面如果内侧出现发霉、起皮的现象,多是窗户密封不够严密,周围渗水了。需要把密封胶铲掉,重新加固密封。

要是冬季外墙内侧的墙角严重发霉,大都是因为室内温暖的空气遇到冰冷的墙体,凝结成了水珠造成的。所以再做一层内保温,避免墙体和室温相差太大就能解决。

要是发霉已经很严重了,整面墙已经看不出原来的颜色了,那就别挣扎了,做墙壁翻新吧。重新做墙壁防水,选择具有防霉作用的涂料,以后的日子就不必活在霉菌漫天的世界里了。

快点拿起防霉*器武**保护自己,这样才能有底气对霉菌说一声,无所谓,“霉”关系,反正我会灭了你~
(转载来源:在家ZAIJIA)